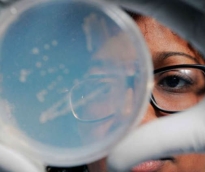
alsharq

أصدرت الخطوط الجوية القطرية تنبيهاً هاماً للمسافرين على متن الرحلتين QR914 وQR915 بين الدوحة وأوكلاند التأكد من حصولهم على تأشيرة أسترالية سارية المفعول،...
رئيس مجلس الإدارة : د. خالد بن ثاني آل ثاني

رئيس التحرير: جابر سالم الحرمي

مساحة إعلانية

تسعى شركات الإلكترونيات باستمرار إلى زيادة مقاسات الشاشات بالهواتف الذكية وأجهزة التلفاز، نظراً لإقبال العملاء على مثل هذه الموديلات، بينما تأتي الحواسب اللوحية وأجهزة اللاب توب بشاشات ذات مقاس أصغر، لأنها تكون أكثر أناقة. وغالباً ما يتم قياس قُطر الشاشة بوحدة البوصة، ما يعادل 2.54 سم، ولكن مقاس القُطر لا يمثل بالضرورة المعيار المثالي، نظراً لأن الشاشات يمكن أن تأتي بأحجام مختلفة، على الرغم من تمتعها بنفس القطر. وفي السابق كانت هناك قاعدة عامة تنص على أن المسافة المثالية بين المشاهد وشاشة التلفاز يجب أن تبلغ من 3 إلى 6 أضعاف مقاس قُطر الشاشة. غير أن تيم هوفمان، من الرابطة الألمانية للاتصالات وتكنولوجيا المعلومات "Bitkom" بالعاصمة الألمانية برلين، أوضح أن هذه القاعدة عفا عليها الزمن. وأضاف هوفمان قائلاً: "تتمتع الشاشات حالياً بدقة وضوح فائق، ولذلك يكفي أن تكون المسافة بين المشاهد والشاشة من ضعفين إلى 3 أضعاف مقاس قُطر الشاشة"، فإذا كان مقاس الشاشة مثلاً 55 بوصة، فإن الحد الأدنى للمسافة بين التلفاز والشاشة يكون أقل من 3 أمتار. حد أدنى للمسافة وبالنسبة للشاشات الأخرى، لا توجد أي قاعدة عامة فيما يتعلق بالمقاس، ولكن هناك حد أدنى للمسافة، حيث أوضحت طبيبة العيون الألمانية كريستل هوبر ذلك، بقولها: "يجب أن يبتعد المستخدم عن الشاشة مسافة 40 سم". وعند استعمال الشاشات الأكبر يمكن أن تبلغ المسافة 80 سم. وتنصح طبيبة العيون الألمانية بعدم التحديق في الشاشة لفترة طويلة؛ نظراً لأن تحريك عضلات العين يساعد على تحفيز الغدة الدمعية، وبالتالي جفاف العين. المقاس حسب الغرض وأوضح تيم هوفمان أن مقاس شاشة الهاتف الذكي أو جهاز اللاب توب يتوقف على الغرض من استعمال هذه الأجهزة الجوالة، وأضاف الخبير الألماني قائلاً: "إذا كان المستخدم يحتاج إلى هاتف ذكي لإجراء المكالمات الهاتفية فقط، ففي هذه الحالة تكفيه الموديلات ذات الشاشات الصغيرة، أما إذا كان يرغب في استعمال الهاتف الذكي لتصفح مواقع الويب في كثير من الأحيان، فينبغي ألا يقل مقاس شاشة الجهاز الجوال عن 4 بوصات". دقة الوضوح ولكن مقاس الشاشة ليس هو المعيار الحاسم عند اختيار شاشة الهواتف الذكية والحواسب اللوحية، ولكن دقة وضوح الشاشة تحظى بأهمية كبيرة أيضاً. وأثبت اختبار لمجلة "إلكترونيك براكسيس" الألمانية، أن عدد البيكسلات يؤثر على جودة الصورة. وعادةً ما تأتي أجهزة اللاب توب بشاشات ذات مقاس يتراوح بين 13 و17 بوصة. ويتوقف مقاس الشاشة المناسب على الغرض من استعمال جهاز اللاب توب، فإذا رغب المستخدم في الاعتماد على جهاز اللاب توب كبديل للحواسب المكتبية، فلا بد من اختيار موديلات بشاشة أكبر. أما إذا كان المستخدم كثير التنقل، فيلزم جهاز لاب توب بشاشة أصغر، لأن ذلك يقلل من وزن الجهاز بطبيعة الحال.
1535
| 04 يونيو 2014

منح المكتب الأمريكي لبراءات الاختراع والعلامات التجارية شركة أبل براءة اختراع تسمح لها بتطوير أنظمة شحن بالطاقة الشمسية لأجهزتها المزودة بشاشات تعمل باللمس. وتعتبر براءة الاختراع الأخيرة نسخة مطورة من براءة اختراع كانت أبل تقدمت بهما إلى المكتب في سبتمبر 2008، لكن البراءة الأخرى مرتبطة بالأجهزة الأقل تطورا من الهواتف الذكية المعاصرة، حسب موقع "أبل إنسايدر". ووفقا لبراءة الاختراع الحديثة، يمكن لأبل تزويد أجهزتها بخلايا شمسية بين طبقات شاشة اللمس، لتشكل نظاما متكاملا للشحن بالطاقة الشمسية، يمكنه تخزين الطاقة في بطاريات الأجهزة، سواء المزودة بشاشات زجاجية أو بلاستيكية مرنة. ومن شأن هذه البراءات تعزيز احتمالات اعتماد أبل على الطاقة الشمسية في منتجاتها المقبلة، ومن بينها ساعتها الذكية المنتظرة "آي ووتش".
359
| 21 مايو 2014
رغم النظافة التي تبدو عليها الهواتف الذكية أو الحواسيب اللوحية، إلا أن دراسات حديثة وجدت أن آلاف الجراثيم تعيش على أسطح الشاشات التي تعمل باللمس، ويمكنها المساعدة على نشر البق وإصابة الأشخاص بالإسهال. ولمواجهة تلك المشكلة المقززة، تم مؤخراً تطوير أول شاشة مضادة للبكتيريا في العالم يمكنها قتل الجراثيم. قامت شركة Corning، التي تقف وراء شاشات الهواتف فائقة القوة المصنوعة من زجاج "غوريلا"، بتصنيع تلك الشاشة الجديدة التي تتسم بفعاليتها في مكافحة البكتيريا التي تلتصق على الشاشات. وأوضحت الشركة أنها زودت الشاشة بالفضة الأيونية المضادة للبكتيريا، وهي قادرة بالفعل على قتل ما يصل إلى 99.9 % من الجراثيم. وعلى عكس الرذاذات المضادة للبكتيريا المتوافرة حالياً، لا يمكن لتلك الفضة أن تزول ولا يمكن مسحها كذلك. ونوهت بهذا الخصوص صحيفة الدايلي ميل البريطانية، إلى أن الزجاج معروض حالياً في معرض إلكترونيات المستهلك بلاس فيجاس، وأنه يخضع للاختبار حالياً من جانب عدة مصنعين. وأضافت الصحيفة أن هذا الزجاج قد يستخدم يوماً ما في النوافذ، قطع أثاث أماكن العمل، شاشات عرض الهواتف الذكية، الحواسيب اللوحية، الآلات الحاسبة وأشياء أخرى عديدة. وقال جيمس شتاينر نائب الرئيس الأول والمدير العام لدى الشركة " يعمل زجاج غوريلا المضاد للميكروبات على وقف نمو الطحالب، العفن، الفطريات والبكتيريا بفضل ما تتميز به من خواص داخلية مضادة للميكروبات، تعتبر جوهرية بالنسبة للزجاج وفعالة بالنسبة لعمر الأجهزة". كما أشارت الشركة إلى أنها تمكنت من إضافة السمة الخاصة بمكافحة الميكروبات من دون إضعاف الزجاج، ولأن الشاشة مقاومة للخدش أيضاً، لا يمكن للميكروبات أن تعيش في الشقوق. ويستخدم زجاج "جوريلا" حالياً في هواتف سامسونج جالاكسي، وكذلك في هاتف نيكسس 7 من جوجل و10 حواسيب لوحية وتلفزوينات سوني برافيا موديلي إن إكس وإتش إكس، وتستخدم الفضة الأيقونية حالياً في المستشفيات وتحظى باستخدامات طبية أخرى.
270
| 08 يناير 2014
مساحة إعلانية
الأكثر مشاهدة

أكدت الدكتورة رانية محمد، مدير إدارة المدارس ورياض الأطفال الخاصة والقائم بمهام التراخيص الخاصة بوزارة التربية والتعليم والتعليم العالي، أن السياسة الجديدة لتنظيم...
25354
| 11 يونيو 2026

تنطلق بعد ساعات بطولة كأس العالم 2026، في نسخة تُعد الأكبر والأكثر استثنائية في تاريخ البطولة، فللمرة الأولى منذ انطلاق المونديال، تشهد المنافسات...
17912
| 10 يونيو 2026

يمكن للمنشأة التقدم بطلب إعارة لعامل من منشأته الحالية لمنشأة أخرى لفترة من الوقت دون الحاجة إلى تغيير جهة العمل، حيث يمكن للعامل...
8088
| 10 يونيو 2026

حمل تطبيق الشرق
تابع الأخبار المحلية والعالمية من خلال تطبيقات الجوال المتاحة على متجر جوجل ومتجر آبل
الأكثر رواجاً
- 1 للمقيمين وفي 5 خطوات فقط.. كيف تحدث بيانات جواز السفر عبر مطراش؟
أوضحت وزارة الداخلية أن تطبيق مطراش يتيح للمقيمين خدمة تحديث بيانات جواز السفر في حال تجديده بسهولة، دون الحاجة إلى مراجعة مراكز الخدمات...
4968
| 10 يونيو 2026
- 2 حمد دلموك الوكيل المساعد لشؤون العمالة الوافدة بـ "العمل" في حوار شامل لـ الشرق: رقابة مشددة على مكاتب الاستقدام وإجراءات قانونية تصل لسحب تراخيص المخالفين
تطوير التشريعات والتحول الرقمي والرقابة ركائز استدامة سوق العمل مراجعة دورية للتشريعات المنظمة لسوق العمل لضمان حصول العامل على حقوقه الكاملة نقلة نوعية...
4418
| 11 يونيو 2026
- 3 أمريكانا للمطاعم تفتتح أول متجر carpo في قطر
• يفتح أول متجر carpo في قطر أبوابه في فيو دوم، المنطقة الفاخرة بالقرب من البوابة السادسة في فيلاجيو مول • يُقدّم المتجر...
3752
| 10 يونيو 2026



